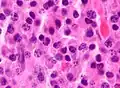
Micrograph of a plasmacytoma, H&E stain

Multiple myeloma
| Multiple myeloma | |
|---|---|
| Other names | Plasma cell myeloma, myelomatosis, Kahler's disease, myeloma[1] |
_MG_stain.jpg) | |
| Bone marrow sample from a patient with multiple myeloma | |
| Specialty | Hematology and oncology |
| Symptoms | Bone pain, fatigue[2]: 653 |
| Complications | Amyloidosis, kidney problems, bone fractures, hyperviscosity syndrome, infections, anemia[3][2]: 653 |
| Usual onset | Around 60 |
| Duration | Long term[3] |
| Causes | Unknown[4] |
| Risk factors | Obesity[5] |
| Diagnostic method | Blood or urine tests, bone marrow biopsy, medical imaging[6] |
| Treatment | Steroids, chemotherapy, thalidomide, stem cell transplant, bisphosphonates, radiation therapy[3][6] |
| Prognosis | Five-year survival rate 62% (US, 2015–2021) [7] |
| Frequency | 488,200 (affected during 2015)[8] |
| Deaths | 101,100 (2015)[9] |
Multiple myeloma (MM), also known as plasma cell myeloma and simply myeloma, is a cancer of plasma cells, a type of white blood cell that normally produces antibodies.[6] Often, no symptoms are noticed initially.[10] As it progresses, bone pain, anemia, renal insufficiency, and infections may occur.[10] Complications may include hypercalcemia and amyloidosis.[3]
The cause of multiple myeloma is unknown.[4] Risk factors include obesity, radiation exposure, family history, age and certain chemicals.[5][11][12] There is an increased risk of multiple myeloma in certain occupations,[13] due to occupational exposure to aromatic hydrocarbon solvents.[14] Multiple myeloma is the result of a multi-step malignant transformation, and almost universally originates from the pre-malignant stage monoclonal gammopathy of undetermined significance (MGUS). As MGUS evolves into MM, another pre-stage of the disease is reached, known as smoldering myeloma (SMM).[15]
In MM, the abnormal plasma cells produce abnormal antibodies, which can cause kidney problems and overly thick blood.[10] The plasma cells can also form a mass in the bone marrow or soft tissue.[10] When one tumor is present, it is called a plasmacytoma; more than one is called multiple myeloma.[10] Multiple myeloma is diagnosed based on blood or urine tests finding abnormal antibody proteins (often using electrophoretic techniques revealing the presence of a monoclonal spike in the results, termed an m-spike), bone marrow biopsy finding cancerous plasma cells, and medical imaging finding bone lesions.[6] Another common finding is high blood calcium levels.[6]
Multiple myeloma is considered treatable, but generally incurable.[3] Remissions may be brought about with steroids, chemotherapy, targeted therapy, and stem cell transplant.[3] Bisphosphonates and radiation therapy are sometimes used to reduce pain from bone lesions.[3][6] New approaches utilizing CAR-T cell therapy have been included in the treatment regimens.[16]
Globally, about 175,000 people were diagnosed with the disease in 2020, while about 117,000 people died from the disease that year. In the U.S., forecasts suggest about 35,000 people will be diagnosed with the disease in 2023, and about 12,000 people will die from the disease that year.[17] In 2020, an estimated 170,405 people were living with myeloma in the U.S.[18] Based on data from people diagnosed with the disease in the United States between 2015 and 2021, about 62% lived five years or more post-diagnosis.[7]
The disease usually occurs around the age of 60 and is more common in men than women.[6] It is uncommon before the age of 40.[6] The word myeloma is from Greek myelo- 'marrow' and -oma 'tumor'.[19]
Signs and symptoms

By the time most people are diagnosed with multiple myeloma, they have symptoms caused by cancer cells growing within the bone marrow.[20] More than 80% have symptoms of bone damage at the time of diagnosis; this can manifest as bone pain and fractures.[21] Bone pain can occur anywhere in the body, but most often involves the back, hips, or skull.[22] Weakened bones in the spine can collapse, causing spinal cord compression that results in sudden back pain as well as numbness or weakness in the limbs.[22] The breakdown of bone also leads to the release of calcium ions into the blood, leading to hypercalcemia and its associated symptoms.[23]
Anemia
The anemia found in myeloma is usually normocytic and normochromic. It results from the replacement of normal bone marrow by infiltrating tumor cells and inhibition of normal red blood cell production (hematopoiesis) by cytokines.[24]
Impaired kidney function
Impaired kidney function may develop, either acutely or chronically, and with any degree of severity.[25][26] The most common cause of kidney failure in multiple myeloma is due to proteins secreted by the malignant cells. Myeloma cells produce monoclonal proteins of varying types, most commonly immunoglobulins (antibodies) and free light chains, resulting in abnormally high levels of these proteins in the blood. Depending on the size of these proteins, they may be excreted through the kidneys. These proteins and light chains can damage the kidneys. Increased bone resorption leads to hypercalcemia and causes nephrocalcinosis, thereby contributing to kidney failure. Amyloidosis is a distant third in the causation. People with amyloidosis have high levels of amyloid protein that can be excreted through the kidneys and cause damage to the kidneys and other organs.[27][28]
Light chains produce myriad effects that can manifest as the Fanconi syndrome (type II kidney tubular acidosis).[27]
Infection
Collateral infections are common with multiple myeloma since the disease impairs the functioning of blood components that normally resist pathogens. The most common infections are pneumonia, urinary tract infections, and sepsis.[29] The greatest risk period for the occurrence of infection is in the initial few months after the start of new drug therapy, since many drug therapies further suppress the normal immune response.[30]
Infections (and "adverse events" for all diseases) are graded by a standardized scale.[31] With some myeloma drug therapies, over 30% of people experience a "Grade 3" or higher infection (many people experience multiple such infections),[32] calling for intervention at least by antibiotics.[31] Of people who die within six months of their myeloma diagnosis, between 20% and 50% die from collateral infections.[29]
Clinical evaluation of a person's immune response is typically performed by a lab test that measures the levels of different immunoglobulins in the blood. There are five varieties of immunoglobulins, indicated by the suffices -A, -D, -E, -G and -M.[33] In the aggregate, the immunoglobulin level may be elevated with the disease, but the majority of such increased antibodies are of a monoclonal variety due to the clonal plasma cell and are thus ineffective. Such ineffective antibodies are common of the immunoglobulin -A and -G varieties.[33] When the measure of effective antibodies drops below a threshold (a condition termed hypogammaglobulinemia),[34] supplemental immunoglobulins may be provided by periodic infusions to reduce the risk of collateral infections.[32]
Neurological symptoms
Some symptoms (e.g., weakness, confusion, and fatigue) may be due to anemia or hypercalcemia. Headache, visual changes, and retinopathy may be the result of hyperviscosity of the blood depending on the properties of the paraprotein. Finally, radicular pain, loss of bowel or bladder control (due to involvement of spinal cord leading to cord compression) or carpal tunnel syndrome, and other neuropathies (due to infiltration of peripheral nerves by amyloid) may occur. It may give rise to paraplegia in late-presenting cases.
When the disease is well-controlled, neurological symptoms may result from current treatments, some of which may cause peripheral neuropathy, manifesting itself as numbness or pain in the hands, feet, and lower legs.
Mouth
The initial symptoms may involve pain, numbness, swelling, expansion of the jaw, tooth mobility, and radiolucency.[35] Multiple myeloma in the mouth can mimic common tooth problems such as periapical abscess or periodontal abscess, gingivitis, periodontitis, or other gingival enlargement or masses.[36]
Cause
The cause of multiple myeloma is generally unknown.[4]
Risk factors
- Monoclonal gammopathy of undetermined significance (MGUS) increases the risk of developing multiple myeloma. MGUS transforms to multiple myeloma at the rate of 1% to 2% per year, and almost all cases of multiple myeloma are preceded by MGUS.[37]
- Smoldering multiple myeloma increases the risk of developing multiple myeloma. Individuals diagnosed with this premalignant disorder develop multiple myeloma at a rate of 10% per year for the first five years, 3% per year for the next five years, and then 1% per year.[38][39]
- Obesity is related to multiple myeloma with each increase of body mass index by five increasing the relative risk by 11%. In addition, studies have shown a positive correlation between BMI and adhesion of multiple myeloma cells.[40]This is due, in part, to cross-talk at a cellular level between fat cells and multiple myeloma cells leading to drug resistance.[41]
Studies have reported a familial predisposition to myeloma.[42][43] Hyperphosphorylation of several proteins—the paratarg proteins—a tendency that is inherited in an autosomal dominant manner, appears to be a common mechanism in these families. This tendency is more common in African Americans with myeloma and may contribute to the higher rates of myeloma in this group.[42]
Occupations
In a study to investigate the association between occupational exposure to aromatic hydrocarbon solvents (benzene and its many derivatives), evidence has shown that these solvents have a role in the causation of multiple myeloma.[14] The occurrence of multiple myeloma may be more common in certain occupations. The risk of multiple myeloma incidence is higher in occupations such as firefighting, hairdressing, and agricultural and industrial work.[44] The risk in certain occupations is due to exposure to different chemicals. Repeated exposure to chemicals increases the risk of multiple myeloma. The use of pesticides and hazardous chemicals in occupations, like firefighting and agriculture, has been seen to cause an increase in risk for multiple myeloma.[13] Other occupations, such as industrial occupations, are also at increased risk for multiple myeloma. Industrial workers are exposed to chemicals containing aromatic hydrocarbon solvents.[14][13]
Exposure to aromatic hydrocarbon solvents, benzene, toluene, and xylene, can increase risk of multiple myeloma. Increased duration, high intensity of exposure, or repeated exposure was associated with an increased risk of multiple myeloma by up to 63%.[14] The time from exposure to diagnosis was studied, and diagnosis after exposure lagged at least 20 years.[14] When exposure to one chemical was identified, there was usually exposure to another hydrocarbon solvent identified.[14] Multiple myeloma affects more men, older adults, and African Americans. These populations also have higher exposure frequencies than their female counterparts.[14]
Epstein–Barr virus
Rarely, Epstein–Barr virus (EBV) is associated with multiple myeloma, particularly in individuals who have an immunodeficiency due to HIV/AIDS, organ transplantation, or a chronic inflammatory condition such as rheumatoid arthritis.[45] EBV-positive multiple myeloma is classified by the World Health Organization (2016) as one form of the Epstein–Barr virus-associated lymphoproliferative diseases and termed Epstein–Barr virus-associated plasma cell myeloma. EBV-positive disease is more common in the plasmacytoma rather than the multiple myeloma form of plasma cell cancer.[46] Tissues involved in EBV+ disease typically show foci of EBV+ cells with the appearance of rapidly proliferating immature or poorly differentiated plasma cells.[46] The cells express products of EBV genes such as EBER1 and EBER2.[47] While the EBV contributes to the development and/or progression of most Epstein–Barr virus-associated lymphoproliferative diseases, its role in multiple myeloma is not known.[48] However, people who are EBV-positive with localized plasmacytoma(s) are more likely to progress to multiple myeloma compared to people with EBV-negative plasmacytoma(s). This suggests that EBV may have a role in the progression of plasmacytomas to systemic multiple myeloma.[47]
Pathophysiology

B lymphocytes start in the bone marrow and move to the lymph nodes. As they progress, they mature and display different proteins on their cell surfaces (cell surface antigens). When they are activated to secrete antibodies, they are known as plasma cells.[49]
Multiple myeloma develops in B lymphocytes after they have left the part of the lymph node known as the germinal center. The normal cell type most closely associated with MM cells is generally taken to be either an activated memory B cell or the precursor to plasma cells, the plasmablast.[50]
The immune system keeps the proliferation of B cells and the secretion of antibodies tightly controlled. When chromosomes and genes are damaged, often through rearrangement, this control is lost. Often, a promoter gene moves (or translocates) to a chromosome, where it stimulates an antibody gene to overproduction.
A chromosomal translocation between the immunoglobulin heavy chain gene (on chromosome 14, locus q32) and an oncogene (often 11q13, 4p16.3, 6p21, 16q23 and 20q11[51]) is frequently observed in people with multiple myeloma. This mutation causes dysregulation of the oncogene, which appears to be an important initiating event in the pathogenesis of myeloma.[52] The result is a proliferation of a plasma cell clone and genomic instability that leads to further mutations and translocations. The chromosome 14 abnormality is observed in about 50% of all cases of myeloma. Deletion of (parts of) chromosome 13 is also observed in about 50% of cases.
Production of cytokines[53] (especially IL-6) by the plasma cells causes much of their localized damage, such as osteoporosis, and creates a microenvironment in which the malignant cells thrive. Angiogenesis (the generation of new blood vessels) is increased.
The produced antibodies are deposited in various organs, leading to kidney failure, polyneuropathy, and various other myeloma-associated symptoms.
Myeloma bone disease is due to the overexpression of receptor activator for nuclear factor κ B ligand (RANKL) by bone marrow stroma. RANKL activates osteoclasts, which resorb bone. The resultant bone lesions are lytic (cause breakdown) in nature. They are best seen in plain radiographs, which may show "punched-out" resorptive lesions (including the "raindrop" appearance of the skull on radiography).
Epigenetics
Epigenetic modifications, as DNA methylation or histone modifications, are key to disease establishment and progression.[54] In a study that investigated the DNA methylation profile of multiple myeloma cells and normal plasma cells, a gradual demethylation from stem cells to plasma cells was observed, with site-specific gain of methylation.[55] Loss of methylation is associated with gene activation and gain of methylation is correlated with gene silencing. The dysregulated methylation pattern in multiple myeloma results in the activation of specific oncogenes and repression of specific tumor suppressor genes. The observed methylation pattern of CpG within intronic regions with enhancer-related chromatin marks in multiple myeloma is similar to undifferentiated precursor and stem cells. These results may represent a de novo epigenetic reprogramming in multiple myeloma, leading to the acquisition of a methylation pattern related to stemness.[56]
Other studies have identified a multiple myeloma specific gene silencing pattern associated with abnormal histone modifications caused by dysregulation of the polycomb repressive complex 2 (PRC2).[57][58] Increased expression of the PRC2 subunit, EZH2 have been described to be a common feature in multiple myeloma, resulting in an accumulation and redistribution of histone H3 lysine 27 trimethylation which advances with disease severity.[59]
Genetics
Genetic abnormalities in multiple myeloma divide the disease into two main groups: hyperdiploid multiple myeloma and non-hyperdiploid multiple myeloma. Hyperdiploid MM is associated with a good prognosis and includes trisomies of odd-numbered chromosomes. Non-hyperdiploid MM has a worse outcome and is characterized by translocations on chromosome 14, which leads to the expression of oncogenes. These translocations can be t(11;14), t(6;14), t(4;14), t(14;16), t(14;20).[60] Other genetic alterations are 1q amplification, deletion 1p, deletion 17, deletion 13, MYC overexpression, and point mutations in key pathways.
Associated genetic mutations include ATM, BRAF, CCND1, DIS3, FAM46C, KRAS, NRAS and TP53.[61]
Development
The genetic and epigenetic changes occur progressively. The initial change, often involving one chromosome 14 translocation, establishes a clone of bone marrow plasma cells that causes the asymptomatic disorder MGUS, which is a premalignant disorder characterized by increased numbers of plasma cells in the bone marrow or the circulation of a myeloma protein immunoglobulin. Further genetic or epigenetic changes produce a new clone of bone marrow plasma cells, usually descended from the original clone, that causes the more serious, but still asymptomatic, premalignant disorder smoldering multiple myeloma. This myeloma is characterized by a rise in the number of bone marrow plasma cells or levels of the circulating myeloma protein above that seen in MGUS.[62]
Subsequent genetic and epigenetic changes lead to a new, more aggressive clone of plasma cells, which causes further rises in the level of the circulating myeloma protein, further rises in the number of bone marrow plasma cells, or the development of one or more of a specific set of "CRAB" symptoms, which are the basis for diagnosing malignant multiple myeloma and treating the disease.[63]
In a small percentage of multiple myeloma cases, further genetic and epigenetic changes lead to the development of a plasma cell clone that moves from the bone marrow into the circulatory system, invades distant tissues, and thereby causes the most malignant of all plasma cell dyscrasias, plasma cell leukemia.[38][64][65] Thus, a fundamental genetic instability in plasma cells or their precursors leads to the progression:
Monoclonal gammopathy of undetermined significance → smoldering multiple myeloma → multiple myeloma → plasma cell leukemia
Being asymptomatic, monoclonal gammopathy of undetermined significance and smoldering multiple myeloma are typically diagnosed fortuitously by detecting a myeloma protein on serum protein electrophoresis tests done for other purposes. MGUS is a relatively stable condition afflicting 3% of people aged 50 and 5% of people aged 70; it progresses to multiple myeloma at a rate of 0.5–1% cases per year; smoldering multiple myeloma does so at a rate of 10% per year for the first 5 years, but then falls off sharply to 3% per year for the next 5 years and thereafter to 1% per year.[38][39]
Overall, some 2–4% of multiple myeloma cases eventually progress to plasma cell leukemia.[64]
Diagnosis
The CRAB criteria were formerly the benchmark used to establish the presence of active multiple myeloma (as opposed to an earlier, generally asymptomatic, "smoldering" form of the disease). The CRAB criteria are:[66][2][67]
- Calcium: serum calcium >0.25 mmol/L (>1 mg/dL) higher than the upper limit of normal or >2.75 mmol/L (>11 mg/dL)
- Renal insufficiency: creatinine clearance <40 mL per minute or serum creatinine >1.77 mol/L (>2 mg/dL)
- Anemia: hemoglobin value of >2g/dL below the lowest limit of normal, or a hemoglobin value <10g/dL
- Bone lesions: osteolytic lesions on skeletal radiography, CT, or PET/CT
As of 2014 the diagnostic criteria were expanded and updated by the IMWG (International Myeloma Working Group) to add three myeloma-defining events, any one of which indicates the presence of active multiple myeloma. Each of these three events may occur before any of the CRAB criteria appears, thereby making more people eligible for treatment with myeloma drugs earlier.[67]
Blood tests

The globulin level may be normal in established disease. A doctor may request protein electrophoresis of the blood and urine, which might show the presence of a paraprotein (monoclonal protein, or M protein) band, with or without reduction of the other (normal) immunoglobulins (known as immune paresis). One type of paraprotein is the Bence Jones protein, which is a urinary paraprotein composed of free light chains. Quantitative measurements of the paraprotein are necessary to establish a diagnosis and to monitor the disease. The paraprotein is a specific immunoglobulin (or fragment of immunoglobulin) originally produced by the mutated plasma cell, which began to multiply and is now produced by the entire line of malignant cells.[68]
In theory, multiple myeloma can produce all classes of immunoglobulin, but IgG paraproteins are most common, followed by IgA and IgM. IgD and IgE myeloma are very rare. In addition, light and or heavy chains (the building blocks of antibodies) may be secreted in isolation: κ- or λ-light chains or any of the five types of heavy chains (α-, γ-, δ-, ε- or μ-heavy chains). People without evidence of a monoclonal protein may have "nonsecretory" myeloma (not producing immunoglobulins); this represents about 3% of all people with multiple myeloma.[69]
Additional findings may include a raised calcium level (when osteoclasts are breaking down bone, releasing it into the bloodstream), raised serum creatinine level due to reduced kidney function, which is mainly due to casts of paraprotein deposition in the kidney, although the cast may also contain complete immunoglobulins, Tamm–Horsfall protein and albumin.[70]
Other useful laboratory tests include quantitative measurements of IgA, IgG, and IgM to look for immune paresis, and beta-2 microglobulin, which provides prognostic information. On peripheral blood smear, the rouleaux formation of red blood cells is commonly seen, though this is not specific.
The recent introduction of a commercial immunoassay for the measurement of free light chains potentially offers an improvement in monitoring disease progression and response to treatment, particularly where the paraprotein is difficult to measure accurately by electrophoresis (for example, in light chain myeloma, or where the paraprotein level is very low). Initial research also suggests that measuring free light chains may also be used, in conjunction with other markers, for assessment of the risk of progression from MGUS to multiple myeloma.[71]
This assay, the serum free light chain assay, has recently been recommended by the International Myeloma Working Group for the screening, diagnosis, prognosis, and monitoring of plasma cell dyscrasias.[72]
-
_HE_stain.jpg) Bone marrow aspirate showing the histologic correlate of multiple myeloma under the microscope, H&E stain
Bone marrow aspirate showing the histologic correlate of multiple myeloma under the microscope, H&E stain -
 Plasmacytoma, H&E stain
Plasmacytoma, H&E stain -
 Micrograph showing myeloma cast nephropathy in a kidney biopsy: Hyaline casts are PAS positive (dark pink/red – right of image). Myelomatous casts are PAS negative (pale pink – left of image), PAS stain.
Micrograph showing myeloma cast nephropathy in a kidney biopsy: Hyaline casts are PAS positive (dark pink/red – right of image). Myelomatous casts are PAS negative (pale pink – left of image), PAS stain. -
 Atypical plasma cell infiltrate with both Russell (cytoplasmic) and Dutcher (nuclear) bodies (H&E, 50x)
Atypical plasma cell infiltrate with both Russell (cytoplasmic) and Dutcher (nuclear) bodies (H&E, 50x) -
Micrograph of a plasmacytoma, H&E stain
Micrograph of a plasmacytoma, H&E stain
Histopathology
A bone marrow biopsy is usually performed to estimate the percentage of bone marrow occupied by plasma cells. This percentage is used in the diagnostic criteria for myeloma. Immunohistochemistry (staining particular cell types using antibodies against surface proteins) can detect plasma cells that express immunoglobulin in the cytoplasm and occasionally on the cell surface; myeloma cells are often CD56, CD38, CD138, and CD319 positive and CD19, CD20, and CD45 negative.[66] Flow cytometry is often used to establish the clonal nature of the plasma cells, which will generally express only kappa or lambda light chain. Cytogenetics may also be performed in myeloma for prognostic purposes, including a myeloma-specific fluorescent in situ hybridization and virtual karyotype.
The plasma cells seen in multiple myeloma have several possible morphologies. First, they could appear like a normal plasma cell, a large cell two or three times the size of a peripheral lymphocyte. Because they are actively producing antibodies, the Golgi apparatus typically produces a light-colored area adjacent to the nucleus, called a perinuclear halo. The single nucleus (with a single nucleolus with vesicular nuclear chromatin) is eccentric, displaced by an abundant cytoplasm. Other common morphologies seen, but which are not usual in normal plasma cells, include:
- Bizarre cells, which are multinucleated
- Mott cells, containing multiple clustered cytoplasmic droplets or other inclusions (sometimes confused with Auer rods, commonly seen in myeloid blasts)
- Flame cells, having a fiery red cytoplasm[73][74]
Historically, the CD138 has been used to isolate myeloma cells for diagnostic purposes. However, this antigen disappears rapidly ex vivo. Recently, however, the surface antigen CD319 (SLAMF7) was discovered to be considerably more stable and allows robust isolation of malignant plasma cells from delayed or even cryopreserved samples.[75]
The prognosis varies widely depending on various risk factors. The Mayo Clinic has developed a risk-stratification model termed Mayo Stratification for Myeloma and Risk-adapted Therapy (mSMART), which categorizes people into high-risk and standard-risk groups.[76] People with deletion of chromosome 13 or hypodiploidy by conventional cytogenetics, t(4;14), t(14;16), t(14;20) or 17p- by molecular genetic studies, or with a high plasma cell labeling index (3% or more) are considered to have high-risk myeloma.[77]
Medical imaging
The diagnostic examination of a person with suspected multiple myeloma typically includes a skeletal survey. This is a series of X-rays of the skull, axial skeleton, and proximal long bones. Myeloma activity sometimes appears as "lytic lesions" (with local disappearance of normal bone due to resorption) or as "punched-out lesions" on the skull X-ray ("raindrop skull"). Lesions may also be sclerotic, which is seen as radiodense.[78] Overall, the radiodensity of myeloma is between −30 and 120 Hounsfield units (HU).[79] Magnetic resonance imaging is more sensitive than simple X-rays in the detection of lytic lesions. An MRI may supersede a skeletal survey, especially when vertebral disease is suspected. Occasionally, a CT scan is performed to measure the size of soft-tissue plasmacytomas. Nuclear medicine bone scans are typically not of any additional value in the workup of people with myeloma (no new bone formation; lytic lesions not well visualized on nuclear bone scan).
-
 X-ray of the forearm, with lytic lesions
X-ray of the forearm, with lytic lesions -
 Skull X-ray showing multiple lucencies due to multiple myeloma
Skull X-ray showing multiple lucencies due to multiple myeloma -
 Multiple myeloma in the upper arm
Multiple myeloma in the upper arm -
 Pathological fracture of the lumbar spine due to multiple myeloma
Pathological fracture of the lumbar spine due to multiple myeloma -
A CT of the brain revealed a lytic lesion in the left temporal bone (red arrow), and petrous temporal bones involving the mastoid segment of the facial nerve canal (green arrow).
-
 CT scan of the lower vertebral column in a man with multiple myeloma, showing multiple osteoblastic lesions: These are more radiodense (brighter in this image) than the surrounding cancellous bone, in contrast to osteolytic lesions, which are less radiodense.
CT scan of the lower vertebral column in a man with multiple myeloma, showing multiple osteoblastic lesions: These are more radiodense (brighter in this image) than the surrounding cancellous bone, in contrast to osteolytic lesions, which are less radiodense. -
 Femur with multiple myeloma lesions
Femur with multiple myeloma lesions -
 Same femur before myeloma lesions for comparison
Same femur before myeloma lesions for comparison -
 Humerus with multiple myeloma lesions
Humerus with multiple myeloma lesions -
 Same humerus before, with just subtle lesions
Same humerus before, with just subtle lesions
Diagnostic criteria
In 2003, the IMWG[66] agreed on diagnostic criteria for symptomatic myeloma, asymptomatic myeloma, and MGUS, which was subsequently updated in 2009:[80]
- Symptomatic myeloma (all three criteria must be met):
- Clonal plasma cells >10% on bone marrow biopsy or (in any quantity) in a biopsy from other tissues (plasmacytoma)
- A monoclonal protein (myeloma protein) in either serum or urine, and it has to be more than 3g/dL (except in cases of true nonsecretory myeloma)
- Evidence of end-organ damage felt related to the plasma cell disorder (related organ or tissue impairment, CRAB):
- HyperCalcemia (corrected calcium >2.75 mmol/L, >11 mg/dL)
- Renal failure (kidney insufficiency) attributable to myeloma
- Anemia (hemoglobin <10 g/dL)
- Bone lesions (lytic lesions or osteoporosis with compression fractures).[a]
In 2014, the IMWG updated its criteria further to include biomarkers of malignancy.[72][81] These biomarkers are >60% clonal plasma cells, a serum involved / uninvolved free light chain ratio ≥ 100 (the concentration of the involved free light chain must be ≥ 100 mg/L) and more than one focal lesion ≥ 5 mm by MRI.[72][81] Together, these biomarkers and the CRAB criteria are known as myeloma-defining events (MDEs). A person must have >10 % clonal plasma cells and any MDE to be diagnosed with myeloma.[72] The biomarker criteria were added so that smouldering people with multiple myeloma at high risk of developing multiple myeloma could be diagnosed before organ damage occurred, so they would therefore have a better prognosis.[81]
- Asymptomatic/smoldering myeloma:
- Serum M protein >30 g/L (3 g/dL) or
- Clonal plasma cells >10% on bone marrow biopsy and
- No myeloma-related organ or tissue impairment
- Monoclonal gammopathy of undetermined significance (MGUS):
- Serum paraprotein <30 g/L (3 g/dL) and
- Clonal plasma cells <10% on bone marrow biopsy and
- No myeloma-related organ or tissue impairment or a related B-cell lymphoproliferative disorder
Related conditions include solitary plasmacytoma (a single tumor of plasma cells, typically treated with irradiation), plasma cell dyscrasia (where only the antibodies produce symptoms, e.g., AL amyloidosis), and peripheral neuropathy, organomegaly, endocrinopathy, monoclonal plasma cell disorder, and skin changes.
Staging
In multiple myeloma, staging helps with prognostication but does not guide treatment decisions. The Durie-Salmon staging system was used historically and was replaced by the International Staging System (ISS), published by the International Myeloma Working Group in 2005.[82] The revised ISS (R-ISS) was published in 2015 and incorporates cytogenetics and lactate dehydrogenase (LDH).[83]: 1730–1 [84][85]: 732–3
- Stage I: β2 microglobulin (β2M) < 3.5 mg/L, albumin ≥ 3.5 g/dL, normal cytogenetics, no elevated LDH
- Stage II: Not classified under Stage I or Stage III
- Stage III: β2M ≥ 5.5 mg/L and either elevated LDH or high-risk cytogenetics [t(4,14), t(14,16), and/or del(17p)]
Prevention
The risk of developing multiple myeloma can be reduced slightly by maintaining a normal body weight.[86]
Treatment
Most drug therapies employ multiple agents, e.g., so-called "triplet" or "quadruplet" therapies. Many such groupings include one or more of a monoclonal antibody (e.g., isatuximab or daratumumab), an immunomodulatory agent (e.g., lenalidomide or pomalidomide), and a proteasome inhibitor (e.g., or bortezomib, carfilzomib or ixazomib), in combination with a steroid (e.g., dexamethasone).[87]
While triplet therapies were the standard of care for many years, current practice more commonly applies quadruplets of drugs.[87] Such combination therapies are commonly referenced by initials, employing upper-case letters for drug brand names and lower-case letters for generic drug names, e.g., VRd for Velcade (brand name for bortezomib), Revlimid (brand name for lenalidomide), and dexamethasone. Similarly with DKRd, with the D representing Darzalex (brand name for daratumumab), and K representing Kyprolis (brand name for carfilzomib).[88] (Emerging practice is not to call such drugs "chemotherapy" because they are not the traditional non-specific intracellular poisons that operate in the classic "chemo" fashion of inhibiting mitosis or inducing DNA damage.[89][90])
Commonly, the efficacy of each drug diminishes over time, as the cancer develops drug resistance mechanisms, such as clonal evolution or genetic mutations. In part for this reason, multiple myeloma has not historically been treated when in its "smoldering" stage, since the drug(s) utilized may then be of diminished efficacy if the disease progresses to a symptomatic stage. Thus, the standard of care was "watchful waiting" while the disease smoldered.[91] Increasingly, however, efforts are underway to study whether drug therapies applied during the smoldering stage might prevent the disease from ever advancing to the active stage. Exemplary are the GEM-CESAR,[92] ASCENT[93] and Immuno-PRISM[94] clinical trials.
After drug therapy has reduced a patient's cancer burden, some patients undergo a bone marrow transplant (more properly termed a autologous hematopoietic stem cell transplant, or ASCT) to suppress the disease further. However, this procedure is not available for frail patients,[95] as it essentially resets aspects of the immune system and requires redevelopment of natural defenses, such as by administering childhood vaccines.[96]
Increasingly, precision medicine therapies are being explored, with research indicating that certain variants and genetic subtypes of the disease respond more favorably to some drug therapies than others.[97] For example, some research indicates that patients with the t(11,14) genetic translocation (present in about 15-20% of multiple myeloma patients) may particularly benefit from Venetoclax therapy (which is FDA approved for other blood cancers but not yet available for multiple myeloma patients except through clinical trials).[97][98]
While drug therapies commonly entail months or years of treatment, CAR-T therapy offers the alternative of a single treatment (albeit involving a prolonged hospital stay). Moreover, CAR-T treatment seems to provide a deeper, longer-lasting disease remission than existing drugs.[99] The FDA originally approved CAR T-Cell therapy only for myeloma patients in later stages of the disease,[100] but in 2024 expanded approval to include patients who have relapsed after only a single line of treatment.[101]
A therapy that also leverages T-cell immune response is the class of drugs termed bispecific T-cell engagers (BITE), or sometimes simply bispecific antibodies. The first drug in this class approved for multiple myeloma is teclistamab, but its use is reserved for people in the later stages of the disease.[102] Another BITE drug, talquetamab is under study.[103]
Treatment is indicated in myeloma with symptoms. If there are no symptoms, but a paraprotein typical of myeloma and diagnostic bone marrow is present without end-organ damage, treatment is usually deferred or restricted to clinical trials.[104] Treatment for multiple myeloma is focused on decreasing the clonal plasma cell population and consequently decrease the symptoms of disease.
Chemotherapy
Initial
The preferred treatment for those under the age of 65 treatment with bortezomib-based regimens, and lenalidomide–dexamethasone,[105] to be followed by high dose chemotherapy and stem cell transplant. A 2016 study concluded that a stem cell transplant is the preferred treatment for multiple myeloma.[106] There are two types of stem cell transplants to treat multiple myeloma.[107] In autologous hematopoietic stem-cell transplantation (ASCT) – the patient's stem cells are collected from the patient's blood. The patient is given high-dose chemotherapy, and the patient's stem cells are then transplanted back into the patient. The process is not curative but does prolong overall survival and complete remission. In allogeneic stem-cell transplantation, a healthy donor's stem cells are transplanted into the affected person. Allogenic stem-cell transplantation has the potential for a cure, but is used in a very small percentage of people (and in the relapsed setting, not as part of initial treatment).[51] Furthermore, a 5–10% treatment-associated mortality rate is associated with allogeneic stem-cell transplant.
People over age 65 and people with significant concurrent illnesses often cannot tolerate stem-cell transplantation. For these people, the standard of care has been chemotherapy with melphalan and prednisone. Recent studies among this population suggest improved outcomes with new chemotherapy regimens, e.g., with bortezomib.[108][109] Treatment with bortezomib, melphalan, and prednisone had an estimated overall survival of 83% at 30 months, lenalidomide plus low-dose dexamethasone an 82% survival at 2 years, and melphalan, prednisone, and lenalidomide had a 90% survival at 2 years. Head-to-head studies comparing these regimens have not been performed as of 2008.[110]
Results of the recently completed ALCYONE 7-year study were published in 2025. This study compared 350 newly diagnosed multiple myeloma patients treated with the standard Velcade, melphalan, and prednisone, i.e., VMP, regimen versus 356 newly diagnosed multiple myeloma patients treated with VMP plus Darzalex, i.e., D-VMP, regimen. All patients were ineligible for autologous stem cell transplantation. During the 9 cycles of treating patients with VMP, D-VMP patients also received intravenous injections of Darzalex (16 mg/kilogram body weight) once weekly in cycle 1, once every 3 weeks in cycles 2-9, and once every 4 weeks thereafter until a patient developed unacceptable toxicity or disease progression or when the study was ended after an average of 86.7 months. The median overall survival time (i.e., time when 50% of the patients were still alive) was 83.0 months for D-MVP patients compared to 53.6 months for VMP patients (p<000.1). There were no significant differences in the adverse responses of the two groups with respect to their development of treatment-related neutropenia, thrombocytopenia, anemia, or other serious adverse drug-related responses. D-VMP-treated patients often had minimal residual disease whereas VMP-treated patients more often had more extensive disease, i.e., D-VMP patients had less disease as defined by having fewer malignant plasma cells in their bone marrow than VMP patients.[111] The MIAI study published in 2022 reported that the addition of Darzalex to treating autologous stem cell transplant-ineligible multiple myeloma patients treated with lenalidomide plus dexamethasone significantly improved their responses.[111][112].
There is support for continuous therapies with multiple drug combinations of antimyeloma drugs bortezomib, lenalidomide, and thalidomide as initial treatment for transplant-ineligible multiple myeloma.[113] Further clinical studies are required to determine the potential harms of these drugs and their effect on the person's quality of life.[113] A 2009 review noted, "Deep venous thrombosis and pulmonary embolism are the major side effects of thalidomide and lenalidomide. Lenalidomide causes more myelosuppression, and thalidomide causes more sedation. Chemotherapy-induced peripheral neuropathy and thrombocytopenia are major side effects of bortezomib."[114] The addition of subcutaneous daratumumab to induction and consolidation therapy with bortezomib, lenalidomide, and dexamethasone, and to lenalidomide maintenance therapy, conferred improved progression-free survival among transplantation-eligible patients with newly diagnosed multiple myeloma.[115]
Treatment of related hyperviscosity syndrome may be required to prevent neurologic symptoms or kidney failure.[116][117]
Maintenance
Most people, including those treated with ASCT, relapse after initial treatment. Maintenance therapy using a prolonged course of low-toxicity medications is often used to prevent relapse. A 2017 meta-analysis showed that post-ASCT maintenance therapy with lenalidomide improved progression-free survival and overall survival in people at standard risk.[118] A 2012 clinical trial showed that people with intermediate- and high-risk disease benefit from a bortezomib-based maintenance regimen.[119]
Relapse
Reasons for relapse include disease evolution, either from the selective pressure applied by treatment or by de novo mutations and/or if the disease was inadequately represented in the initial biopsy.[83] Relapse within the first 18 months of diagnosis is considered as functional high-risk multiple myeloma.[83] Depending on the person's condition, the prior treatment modalities used, and the duration of remission, options for relapsed disease include retreatment with the original agent, use of other agents (such as melphalan, cyclophosphamide, thalidomide, or dexamethasone, alone or in combination), and a second ASCT.
Later in the course of the disease, it becomes refractory (resistant) to formerly effective treatment. This stage is referred to as relapsed/refractory multiple myeloma (RRMM). Treatment modalities that are commonly used to treat RRMM include dexamethasone, proteasome inhibitors (e.g. bortezomib and carfilzomib), immunomodulatory imide drugs (e.g. thalidomide, lenalidomide, and pomalidomide), and certain monoclonal antibodies (e.g. isatuximab against CD38 or antibodies targeting CD319). Survival expectancy has risen in recent years,[120] and new treatments are under development.
Kidney failure in multiple myeloma can be acute (reversible) or chronic (irreversible). Acute kidney failure typically resolves when the calcium and paraprotein levels are brought under control. Treatment of chronic kidney failure is dependent on the type of kidney failure and may involve dialysis.
Several newer options are approved for the management of advanced disease:
- belantamab mafodotin: a monoclonal antibody against B-cell maturation antigen (BCMA), also known as CD269, indicated for the treatment of adults with relapsed or refractory multiple myeloma who have received at least four prior therapies including an anti-CD38 monoclonal antibody, a proteasome inhibitor, and an immunomodulatory agent.[121][122]
- carfilzomib: a proteasome inhibitor that is indicated:
- as a single agent in people who have received one or more lines of therapy
- in combination with dexamethasone or with lenalidomide and dexamethasone in people who have received one to three lines of therapy[123]
- daratumumab: a monoclonal antibody against CD38 indicated in people who have received at least three prior lines of therapy including a proteasome inhibitor and an immunomodulatory agent or who are double refractory to a proteasome inhibitor and an immunomodulatory agent[124]
- elotuzumab: an immunostimulatory humanized monoclonal antibody against SLAMF7 (also known as CD319) indicated in combination with lenalidomide and dexamethasone in people who have received one to three prior therapies[125]
- isatuximab: a monoclonal antibody against CD38 indicated in combination with pomalidomide and dexamethasone for the treatment of adults with multiple myeloma who have received at least two prior therapies including lenalidomide and a proteasome inhibitor.[126][127]
- ixazomib: an orally available proteasome inhibitor indicated in combination with lenalidomide and dexamethasone in people who have received at least one prior therapy[128]
- panobinostat: an orally available histone deacetylase inhibitor used in combination with bortezomib and dexamethasone in people who have received at least two prior chemotherapy regimens, including bortezomib and an immunomodulatory agent[129]
- selinexor: an orally available selective inhibitor of nuclear export indicated in combination with dexamethasone in people who have received at least four prior therapies and whose disease does not respond to at least two proteasome inhibitors, two immunomodulatory agents and an anti-CD38 monoclonal antibody[130]
- idecabtagene vicleucel: first cell-based gene therapy was approved by FDA in 2021 for the treatment of adults with relapsed or refractory multiple myeloma who have received at least four prior therapies[131]
Talquetamab (Talvey) and elranatamab (Elrexfio) were approved for medical use in the United States in August 2023.[132][133][134][135]
Stem cell transplant
Stem cell transplant can be used to treat multiple myeloma, either using one's own stem cells (autograft) or from a donor (allograft).[3] Allografts come with a particular risk of a graft-versus-host-disease. Mesenchymal stromal cells may reduce all-cause mortality if they are used for a therapeutic reason, and the therapeutic use of MSCs may increase the complete response of acute and chronic GvHD, but the evidence is very uncertain.[136] The evidence suggests that MSCs for prophylactic reason result in little to no difference in all-cause mortality, in the relapse of malignant diseases, and in the incidence of acute GvHD.[136] The evidence suggests that MSCs for prophylactic reason reduce the incidence of chronic GvHD.[136]
CAR-T cell therapy
Two CAR T cell platforms have been approved in multiple myeloma:
- Idecabtagene vicleucel (Abecma) – first cell-based gene therapy was approved by FDA in 2021 for the treatment of adults with relapsed or refractory multiple myeloma who have received at least four prior therapies[131]
- Ciltacabtagene autoleucel (Carvykti) was approved for medical use in the United States in February 2022.[137] Ciltacabtagene autoleucel is indicated for the treatment of adults with relapsed or refractory multiple myeloma after four or more prior lines of therapy, including a proteasome inhibitor, an immunomodulatory agent, and an anti-CD38 monoclonal antibody.[137]
Other measures
In addition to direct treatment of the plasma cell proliferation, bisphosphonates (e.g., pamidronate or zoledronic acid) are routinely administered to prevent fractures; they have also been observed to have a direct antitumor effect even in people without known skeletal disease. If needed, red blood cell transfusions or erythropoietin can be used for management of anemia.
Side effects
Chemotherapies and stem cell transplants can cause unwanted bleeding and may require platelet transfusions. It was seen that platelet transfusions for people undergoing chemotherapy or stem cell transplantation for the prevention of bleeding events had different effects on the number of participants with a bleeding event, the number of days on which bleeding occurred, the mortality secondary to bleeding and the number of platelet transfusions depending on the way they were used (therapeutic, depending on a threshold, different dose schedules or prophylactic).[138][139]
Supportive treatment
Adding physical exercises to the standard treatment for adult patients with haematological malignancies like multiple myeloma may result in little to no difference in mortality, in the quality of life, and physical functioning.[140] These exercises may result in a slight reduction in depression.[140] Furthermore, aerobic physical exercises probably reduce fatigue. The evidence is very uncertain about the effect and serious adverse events[140]
Palliative care
Multiple national cancer treatment guidelines recommend early palliative care for people with advanced multiple myeloma at the time of diagnosis and for anyone who has significant symptoms.[141][142]
Palliative care is appropriate at any stage of multiple myeloma and can be provided alongside curative treatment. In addition to addressing symptoms of cancer, palliative care helps manage unwanted side effects, such as pain and nausea related to treatments.[143][144]
Teeth
Oral prophylaxis, hygiene instruction, and elimination of sources of infection within the mouth before beginning cancer treatment can reduce the risk of infectious complications. Before starting bisphosphonate therapy, the person's dental health should be evaluated to assess the risk factors to prevent the development of medication-related osteonecrosis of the jaw (MRONJ). If there are any symptoms or radiographic appearance of MRONJ, such as jaw pain, loose tooth, or mucosal swelling, early referral to an oral surgeon is recommended. Dental extractions should be avoided during the active period of treatment, and the affected tooth should be treated with nonsurgical root canal therapies instead.[145]
Prognosis
Overall the 5-year survival rate is around 54% in the United States.[146]
The international staging system can help to predict survival, with a median survival (in 2005) of 62 months for stage-1 disease, 45 months for stage-2 disease, and 29 months for stage-3 disease.[82] The median age at diagnosis is 69 years.[146]
Genetic testing
SNP array karyotyping can detect copy number alterations of prognostic significance that may be missed by a targeted FISH panel.[147]
The following table outlines the prognostic effect of various genetic findings in multiple myeloma, with chromosomal translocations designated t, followed by standard nomenclature thereof:[148]
| Genetic abnormality | Gene(s) | Incidence among myelomas | Prognostic impact |
|---|---|---|---|
| Deletion/isolated monosomy 13 | RB1, DIS3 | 45–50% | Effect on prognosis is unclear |
| Trisomies | 40–50% | Median overall survival: 7–10 years | |
| 1q21 gain, as an addition to another abnormality | CKS1B, ANP32E | 35–40% | Median overall survival: 5 years |
| t(11;14)(q13;q32) | IgH and CCND1 | 15–20% | Median overall survival: 7–10 years |
| Trisomies plus any one IgH translocation | 15% | May neutralize high risk IgH and del 17p translocations | |
| Hypodiploidy | 13–20% | Unfavorable prognosis, high risk of progression | |
| t(4:14)(p16;q32) | IgH and FGFR3/MMSET | 10–15% | Median overall survival: 5 years |
| 17p deletion, as an addition to another abnormality | TP53 | 10% | Median overall survival: 5 years |
| t(14;16) | IgH and C-MAF | 2–5% | Median overall survival: 5 years |
| t(6;14)(p21;q32) | IgH and CCND3 | 2% | Median overall survival: 7–10 years |
| t(14;20)(q32;q12) | MAFB | 1% | Median overall survival: 5 years |
Epidemiology


Globally, multiple myeloma affected 488,000 people in 2015.[8][9] Around 100,000 people die from the disease each year.[150]
Multiple myeloma is the second-most prevalent blood cancer (10%) after non-Hodgkin's lymphoma.[151] It represents about 1.8% of all new cancers.[7]
Multiple myeloma risk increases with age. Nearly two thirds of those diagnosed are over 65, while less than 1% are under 35.[150][152] The average age at diagnosis is 69 years.[153] Multiple myeloma affects slightly more men than women. Incidence of multiple myeloma differs across ethnic groups: highest in Pacific Islanders and those of African descent, moderate in those of European descent, and lowest in those of Chinese and Japanese descent.[153] For those that do develop multiple myeloma, the disease prognosis and response to therapy are similar across ethnic groups.[153]
United Kingdom
Myeloma is the 17th-most common cancer in the UK: around 4,800 people were diagnosed with the disease in 2011. It is the 16th-most common cause of cancer death: around 2,700 people died of it in 2012.[154]
United States
In the United States in 2025, an estimated 36,110 new cases and 12,030 deaths were reported.[7]
Among African Americans, myeloma is one of the top-10 causes of cancer death.[155]
Other animals
Multiple myeloma has been diagnosed in dogs,[156] cats, and horses.[157]
In dogs, multiple myeloma accounts for around 8% of all haemopoietic tumors. Multiple myeloma occurs in older dogs and is not particularly associated with either males or females. No breeds appear overrepresented in case reviews that have been conducted.[158] Diagnosis in dogs is usually delayed due to the initial nonspecificity and range of clinical signs possible. Diagnosis usually involves bone marrow studies, X-rays, and plasma-protein studies. In dogs, protein studies usually reveal the monoclonal gammaglobulin elevation to be IgA or IgG in an equal number of cases.[158] In rare cases the globulin elevation is IgM, which is referred to as Waldenström's macroglobulinemia.[159] The prognosis for initial control and return to good quality of life in dogs is good; 43% of dogs started on a combination chemotherapeutic protocol achieved complete remission. Long-term survival is normal, with a median of 540 days reported.[158] The disease eventually recurs, becoming resistant to available therapies. The complications of kidney failure, sepsis, or pain can lead to an animal's death, frequently by euthanasia.
Notes
- ^ Recurrent infections alone in a person who has none of the CRAB features are not sufficient to make the diagnosis of myeloma. People who lack CRAB features, but have evidence of amyloidosis, should be considered as having amyloidosis and not myeloma. CRAB-like abnormalities are common with numerous diseases, and these abnormalities must be felt to be directly attributable to the related plasma cell disorder, and every attempt made to rule out other underlying causes of anemia, kidney failure, etc.
References
- ^ "Myeloma Canada | What is Multiple Myeloma?". Myeloma Canada. Archived from the original on 13 May 2020. Retrieved 17 April 2020.
- ^ a b c Rajkumar SV (2018). "Multiple Myeloma". In Hensley ML, Milowsky MI, Rajkumar SV, Schuetze SM (eds.). ASCO-SEP: Medical Oncology Self-Evaluation Program (7th ed.). Alexandria, VA: American Society of Clinical Oncology. ISBN 978-0-9983747-4-1. OCLC 1080368315.
- ^ a b c d e f g h "Plasma Cell Neoplasms (Including Multiple Myeloma) Treatment (PDQ®)–Health Professional Version". NCI. 29 July 2016. Archived from the original on 4 July 2016. Retrieved 8 August 2016.
- ^ a b c World Cancer Report 2014. World Health Organization. 2014. pp. Chapter 5.13. ISBN 978-92-832-0429-9.
- ^ a b World Cancer Report 2014. World Health Organization. 2014. pp. Chapter 2.3 and 2.6. ISBN 978-92-832-0429-9.
- ^ a b c d e f g h Raab MS, Podar K, Breitkreutz I, Richardson PG, Anderson KC (July 2009). "Multiple myeloma". Lancet. 374 (9686): 324–339. doi:10.1016/S0140-6736(09)60221-X. PMID 19541364. S2CID 12906881.
- ^ a b c d "SEER Stat Fact Sheets: Myeloma". NCI Surveillance, Epidemiology, and End Results Program. Retrieved 7 January 2026.
- ^ a b Vos T, et al. (October 2016). "Global, regional, and national incidence, prevalence, and years lived with disability for 310 diseases and injuries, 1990-2015: a systematic analysis for the Global Burden of Disease Study 2015". Lancet. 388 (10053): 1545–1602. doi:10.1016/S0140-6736(16)31678-6. PMC 5055577. PMID 27733282.
- ^ a b Wang H, et al. (October 2016). "Global, regional, and national life expectancy, all-cause mortality, and cause-specific mortality for 249 causes of death, 1980-2015: a systematic analysis for the Global Burden of Disease Study 2015". Lancet. 388 (10053): 1459–1544. doi:10.1016/s0140-6736(16)31012-1. PMC 5388903. PMID 27733281.
- ^ a b c d e "Plasma Cell Neoplasms (Including Multiple Myeloma)—Patient Version". NCI. 1 January 1980. Archived from the original on 27 July 2016. Retrieved 8 August 2016.
- ^ "Plasma Cell Neoplasms (Including Multiple Myeloma) Treatment". National Cancer Institute. 1 January 1980. Archived from the original on 9 January 2021. Retrieved 28 November 2017.
- ^ Ferri FF (2013). Ferri's Clinical Advisor 2014 E-Book: 5 Books in 1. Elsevier Health Sciences. p. 726. ISBN 978-0-323-08431-4. Archived from the original on 18 August 2023. Retrieved 23 August 2020.
- ^ a b c Georgakopoulou R, Fiste O, Sergentanis TN, Andrikopoulou A, Zagouri F, Gavriatopoulou M, et al. (September 2021). "Occupational Exposure and Multiple Myeloma Risk: An Updated Review of Meta-Analyses". Journal of Clinical Medicine. 10 (18): 4179. doi:10.3390/jcm10184179. PMC 8469366. PMID 34575290.
- ^ a b c d e f g De Roos AJ, Spinelli J, Brown EB, Atanackovic D, Baris D, Bernstein L, et al. (November 2018). "Pooled study of occupational exposure to aromatic hydrocarbon solvents and risk of multiple myeloma". Occupational and Environmental Medicine. 75 (11): 798–806. doi:10.1136/oemed-2018-105154. PMC 9386620. PMID 30121582.
- ^ van de Donk NW, Mutis T, Poddighe PJ, Lokhorst HM, Zweegman S (May 2016). "Diagnosis, risk stratification and management of monoclonal gammopathy of undetermined significance and smoldering multiple myeloma". International Journal of Laboratory Hematology. 38 (Suppl 1): 110–122. doi:10.1111/ijlh.12504. PMID 27161311.
- ^ Martino M, Canale FA, Alati C, Vincelli ID, Moscato T, Porto G, Loteta B, Naso V, Mazza M, Nicolini F, Ghelli Luserna di Rorà A, Simonetti G, Ronconi S, Ceccolini M, Musuraca G (27 May 2021). "CART-Cell Therapy: Recent Advances and New Evidence in Multiple Myeloma". Cancers. 13 (11): 2639. doi:10.3390/cancers13112639. ISSN 2072-6694. PMC 8197914. PMID 34072068.
- ^ "Multiple Myeloma: Statistics". ASCO Cancer.net. March 2023. Archived from the original on 11 June 2023. Retrieved 10 June 2023.
- ^ "Cancer Stat Facts: Myeloma". National Cancer Institute. Archived from the original on 7 May 2020. Retrieved 10 June 2023.
- ^ Diepenbrock NH (2011). Quick Reference to Critical Care. Lippincott Williams & Wilkins. p. 292. ISBN 978-1-60831-464-5. Archived from the original on 21 August 2016.
- ^ van de Donk, Pawlyn & Yong 2021, p. 412.
- ^ Malard et al. 2024, p. 7.
- ^ a b "Signs and Symptoms of Multiple Myeloma". American Cancer Society. 28 February 2025. Retrieved 27 November 2025.
- ^ "Hypercalcemia". The Lecturio Medical Concept Library. Archived from the original on 25 July 2021. Retrieved 11 August 2021.
- ^ Bruns I, Cadeddu RP, Brueckmann I, Fröbel J, Geyh S, Büst S, et al. (September 2012). "Multiple myeloma-related deregulation of bone marrow-derived CD34(+) hematopoietic stem and progenitor cells". Blood. 120 (13): 2620–2630. doi:10.1182/blood-2011-04-347484. PMC 3460684. PMID 22517906.
- ^ Bladé J, Fernández-Llama P, Bosch F, Montolíu J, Lens XM, Montoto S, et al. (September 1998). "Renal failure in multiple myeloma: presenting features and predictors of outcome in 94 patients from a single institution". Archives of Internal Medicine. 158 (17): 1889–1893. doi:10.1001/archinte.158.17.1889. PMID 9759684.
- ^ Knudsen LM, Hippe E, Hjorth M, Holmberg E, Westin J (October 1994). "Renal function in newly diagnosed multiple myeloma--a demographic study of 1353 patients. The Nordic Myeloma Study Group". European Journal of Haematology. 53 (4): 207–212. doi:10.1111/j.1600-0609.1994.tb00190.x. PMID 7957804. S2CID 2861880.
- ^ a b Nasr SH, Said SM, Valeri AM, Sethi S, Fidler ME, Cornell LD, et al. (March 2013). "The diagnosis and characteristics of renal heavy-chain and heavy/light-chain amyloidosis and their comparison with renal light-chain amyloidosis". Kidney International. 83 (3): 463–470. doi:10.1038/ki.2012.414. PMID 23302715.
- ^ Castillo JJ (December 2016). "Plasma Cell Disorders". Primary Care. 43 (4): 677–691. doi:10.1016/j.pop.2016.07.002. PMID 27866585.
- ^ a b Blimark C (January 2015). "Multiple myeloma and infections: a population-based study on 9253 multiple myeloma patients". Haematologica. 100 (1): 107–113. doi:10.3324/haematol.2014.107714. PMC 4281323. PMID 25344526.
- ^ Chapel HM, Lee M (July 1994). "The use of intravenous immune globulin in multiple myeloma". Clinical and Experimental Immunology. 97 (Suppl 1): 21–24. PMC 1550368. PMID 8033429.
- ^ a b "Common Terminology Criteria for Adverse Events (CTCAE), Version 5.0" (PDF). U.S. Dept. of Health and Human Services. 27 November 2017. Archived (PDF) from the original on 19 May 2023. Retrieved 12 June 2023.
- ^ a b Lancman G (15 November 2022). "Infections and Severe Hypogammaglobulinemia in Multiple Myeloma Patients Treated with Anti-BCMA Bispecific Antibodies". Archived from the original on 11 June 2023. Retrieved 11 June 2023.
- ^ a b "Diagnosis of multiple myeloma". Canadian Cancer Society. Archived from the original on 11 June 2023. Retrieved 11 June 2023.
- ^ Hargreaves RM, Lea JR, Griffiths H, Faux JA, Holt JM, Reid C, et al. (March 1995). "Immunological factors and risk of infection in plateau phase myeloma". Journal of Clinical Pathology. 48 (3): 260–266. doi:10.1136/jcp.48.3.260. PMC 502468. PMID 7730490.
- ^ Glick M (January 2015). Glick M (ed.). Burket's oral medicine. PMPH USA. ISBN 978-1-60795-188-9. OCLC 888026338.
- ^ Shah A, Ali A, Latoo S, Ahmad I (June 2010). "Multiple Myeloma presenting as Gingival mass". Journal of Maxillofacial and Oral Surgery. 9 (2): 209–212. doi:10.1007/s12663-010-0050-7. PMC 3244103. PMID 22190790.
- ^ Landgren O, Kyle RA, Pfeiffer RM, Katzmann JA, Caporaso NE, Hayes RB, et al. (May 2009). "Monoclonal gammopathy of undetermined significance (MGUS) consistently precedes multiple myeloma: a prospective study". Blood. 113 (22): 5412–5417. doi:10.1182/blood-2008-12-194241. PMC 2689042. PMID 19179464.
- ^ a b c Dutta AK, Hewett DR, Fink JL, Grady JP, Zannettino AC (July 2017). "Cutting edge genomics reveal new insights into tumour development, disease progression and therapeutic impacts in multiple myeloma". British Journal of Haematology. 178 (2): 196–208. doi:10.1111/bjh.14649. PMID 28466550.
- ^ a b Willrich MA, Murray DL, Kyle RA (January 2018). "Laboratory testing for monoclonal gammopathies: Focus on monoclonal gammopathy of undetermined significance and smoldering multiple myeloma". Clinical Biochemistry. 51: 38–47. doi:10.1016/j.clinbiochem.2017.05.001. PMID 28479151.
- ^ Roberts DL, Dive C, Renehan AG (2010). "Biological mechanisms linking obesity and cancer risk: new perspectives". Annual Review of Medicine. 61: 301–316. doi:10.1146/annurev.med.080708.082713. PMID 19824817.
- ^ Ochiai M, Fierstein S, XsSali F, DeVito N, Purkey LR, May R, Correa-Medina A, Kelley M, Page TD, DeCicco-Skinner K (31 August 2023). "Unlocking Drug Resistance in Multiple Myeloma: Adipocytes as Modulators of Treatment Response". Cancers. 15 (17): 4347. doi:10.3390/cancers15174347. ISSN 2072-6694. PMC 10486466. PMID 37686623.
- ^ a b Koura DT, Langston AA (August 2013). "Inherited predisposition to multiple myeloma". Therapeutic Advances in Hematology. 4 (4): 291–297. doi:10.1177/2040620713485375. PMC 3734900. PMID 23926460.
- ^ Schinasi LH, Brown EE, Camp NJ, Wang SS, Hofmann JN, Chiu BC, et al. (October 2016). "Multiple myeloma and family history of lymphohaematopoietic cancers: Results from the International Multiple Myeloma Consortium". British Journal of Haematology. 175 (1): 87–101. doi:10.1111/bjh.14199. PMC 5035512. PMID 27330041.
- ^ Sergentanis TN, Zagouri F, Tsilimidos G, Tsagianni A, Tseliou M, Dimopoulos MA, Psaltopoulou T (October 2015). "Risk Factors for Multiple Myeloma: A Systematic Review of Meta-Analyses". Clinical Lymphoma, Myeloma & Leukemia. 15 (10): 563–577.e3. doi:10.1016/j.clml.2015.06.003. PMID 26294217.
- ^ Sekiguchi Y, Shimada A, Ichikawa K, Wakabayashi M, Sugimoto K, Ikeda K, et al. (2015). "Epstein-Barr virus-positive multiple myeloma developing after immunosuppressant therapy for rheumatoid arthritis: a case report and review of literature". International Journal of Clinical and Experimental Pathology. 8 (2): 2090–2102. PMC 4396324. PMID 25973110.
- ^ a b Rezk SA, Zhao X, Weiss LM (September 2018). "Epstein-Barr virus (EBV)-associated lymphoid proliferations, a 2018 update". Human Pathology. 79: 18–41. doi:10.1016/j.humpath.2018.05.020. PMID 29885408. S2CID 47010934.
- ^ a b Yan J, Wang J, Zhang W, Chen M, Chen J, Liu W (April 2017). "Solitary plasmacytoma associated with Epstein-Barr virus: a clinicopathologic, cytogenetic study and literature review". Annals of Diagnostic Pathology. 27: 1–6. doi:10.1016/j.anndiagpath.2016.09.002. PMID 28325354.
- ^ Dojcinov SD, Fend F, Quintanilla-Martinez L (March 2018). "EBV-Positive Lymphoproliferations of B- T- and NK-Cell Derivation in Non-Immunocompromised Hosts". Pathogens. 7 (1): 28. doi:10.3390/pathogens7010028. PMC 5874754. PMID 29518976.
- ^ Muthusamy N, Caligiuri MA (2021). "Chapter 73: The Structure of Lymphocytes and Plasma Cells". Williams Hematology (10th ed.). McGraw-Hill Education.
- ^ Federico Caligaris-Cappio, Manlio Ferrarini (1997). Human B Cell Populations. Chemical Immunology. Vol. 67. Switzerland: S. Karger AG. p. 105. ISBN 978-3-8055-6460-1. Archived from the original on 27 May 2016.
- ^ a b Kyle RA, Rajkumar SV (October 2004). "Multiple myeloma". The New England Journal of Medicine. 351 (18): 1860–1873. doi:10.1056/NEJMra041875. PMC 2265446. PMID 15509819.
- ^ Spielmann M, Lupiáñez DG, Mundlos S (July 2018). "Structural variation in the 3D genome". Nature Reviews. Genetics. 19 (7): 453–467. doi:10.1038/s41576-018-0007-0. hdl:21.11116/0000-0003-610A-5. PMID 29692413. S2CID 22325904.
- ^ Tricot G (January 2000). "New insights into role of microenvironment in multiple myeloma". Lancet. 355 (9200): 248–250. doi:10.1016/S0140-6736(00)00019-2. PMID 10675068. S2CID 41876106.
- ^ Kalushkova A, Nylund P, Párraga AA, Lennartsson A, Jernberg-Wiklund H (8 October 2021). "One Omics Approach Does Not Rule Them All: The Metabolome and the Epigenome Join Forces in Haematological Malignancies". Epigenomes. 5 (4): 22. doi:10.3390/epigenomes5040022. ISSN 2075-4655. PMC 8715477. PMID 34968247.
- ^ Yang T, Liu X, Kumar SK, Jin F, Dai Y (January 2022). "Decoding DNA methylation in epigenetics of multiple myeloma". Blood Reviews. 51 100872. doi:10.1016/j.blre.2021.100872. PMID 34384602.
- ^ Agirre X, Castellano G, Pascual M, Heath S, Kulis M, Segura V, et al. (April 2015). "Whole-epigenome analysis in multiple myeloma reveals DNA hypermethylation of B cell-specific enhancers". Genome Research. 25 (4): 478–487. doi:10.1101/gr.180240.114. PMC 4381520. PMID 25644835.
- ^ Kalushkova A, Fryknäs M, Lemaire M, Fristedt C, Agarwal P, Eriksson M, et al. (July 2010). "Polycomb target genes are silenced in multiple myeloma". PLOS ONE. 5 (7) e11483. Bibcode:2010PLoSO...511483K. doi:10.1371/journal.pone.0011483. PMC 2901331. PMID 20634887.
- ^ Agarwal P, Alzrigat M, Párraga AA, Enroth S, Singh U, Ungerstedt J, et al. (February 2016). "Genome-wide profiling of histone H3 lysine 27 and lysine 4 trimethylation in multiple myeloma reveals the importance of Polycomb gene targeting and highlights EZH2 as a potential therapeutic target". Oncotarget. 7 (6): 6809–6823. doi:10.18632/oncotarget.6843. PMC 4872750. PMID 26755663.
- ^ Croonquist PA, Van Ness B (September 2005). "The polycomb group protein enhancer of zeste homolog 2 (EZH 2) is an oncogene that influences myeloma cell growth and the mutant ras phenotype". Oncogene. 24 (41): 6269–6280. doi:10.1038/sj.onc.1208771. PMID 16007202. S2CID 24588617.
- ^ Prideaux SM, Conway O'Brien E, Chevassut TJ (2014). "The Genetic Architecture of Multiple Myeloma". Advances in Hematology. 2014: 1–16. doi:10.1155/2014/864058. ISSN 1687-9104. PMC 3996928. PMID 24803933.
- ^ Weaver CJ, Tariman JD (August 2017). "Multiple Myeloma Genomics: A Systematic Review". Seminars in Oncology Nursing. 33 (3): 237–253. doi:10.1016/j.soncn.2017.05.001. PMID 28729121. S2CID 20956622. Archived from the original on 18 July 2020. Retrieved 13 July 2019.
- ^ Brigle K, Rogers B (August 2017). "Pathobiology and Diagnosis of Multiple Myeloma". Seminars in Oncology Nursing. 33 (3): 225–236. doi:10.1016/j.soncn.2017.05.012. PMID 28688533.
- ^ Rajkumar SV (August 2022). "Multiple Myeloma: 2022 update on Diagnosis, Risk-stratification and Management". American Journal of Hematology. 97 (8): 1086–1107. doi:10.1002/ajh.26590. PMC 9387011. PMID 35560063.
Rajkumar SV (September 2024). "Multiple myeloma: 2024 update on diagnosis, risk-stratification, and management". Am J Hematol. 99 (9): 1802–24. doi:10.1002/ajh.27422. PMC 3629949. PMID 38943315. - ^ a b Fernández de Larrea C, Kyle RA, Durie BG, Ludwig H, Usmani S, Vesole DH, et al. (April 2013). "Plasma cell leukemia: consensus statement on diagnostic requirements, response criteria and treatment recommendations by the International Myeloma Working Group". Leukemia. 27 (4): 780–791. doi:10.1038/leu.2012.336. PMC 4112539. PMID 23288300.
- ^ Simeon V, Todoerti K, La Rocca F, Caivano A, Trino S, Lionetti M, et al. (July 2015). "Molecular Classification and Pharmacogenetics of Primary Plasma Cell Leukemia: An Initial Approach toward Precision Medicine". International Journal of Molecular Sciences. 16 (8): 17514–17534. doi:10.3390/ijms160817514. PMC 4581206. PMID 26263974.
- ^ a b c International Myeloma Working Group (June 2003). "Criteria for the classification of monoclonal gammopathies, multiple myeloma and related disorders: a report of the International Myeloma Working Group". British Journal of Haematology. 121 (5): 749–757. doi:10.1046/j.1365-2141.2003.04355.x. PMID 12780789. S2CID 3195084.
- ^ a b "International Myeloma Working Group (IMWG) criteria for the diagnosis of multiple myeloma". International Myeloma Foundation. 26 October 2014. Archived from the original on 7 December 2022. Retrieved 11 June 2023.
- ^ Lyubimova NV, Timofeev YS, Abaev VM, Votyakova OM, Kushlinskii NE (May 2018). "Immunochemical Diagnosis of Multiple Myeloma". Bulletin of Experimental Biology and Medicine. 165 (1): 84–87. doi:10.1007/s10517-018-4105-y. ISSN 1573-8221. PMID 29797132.
- ^ Lonial S, Kaufman JL (September 2013). "Non-secretory myeloma: a clinician's guide". Oncology. 27 (9): 924–8, 930. PMID 24282993. Archived from the original on 12 January 2018.
- ^ Mitchell, Richard Sheppard, Kumar, Vinay, Abbas, Abul K., Fausto, Nelson (2007). "Multiple myeloma". Robbins Basic Pathology (8th ed.). Philadelphia: Saunders. p. 455. ISBN 978-1-4160-2973-1.
- ^ Rajkumar SV (1 January 2005). "MGUS and smoldering multiple myeloma: update on pathogenesis, natural history, and management". Hematology. American Society of Hematology. Education Program. 2005 (1): 340–345. doi:10.1182/asheducation-2005.1.340. PMID 16304401.
- ^ a b c d Rajkumar SV, Dimopoulos MA, Palumbo A, Blade J, Merlini G, Mateos MV, et al. (November 2014). "International Myeloma Working Group updated criteria for the diagnosis of multiple myeloma". The Lancet. Oncology. 15 (12): e538 – e548. doi:10.1016/s1470-2045(14)70442-5. hdl:2268/174646. PMID 25439696. S2CID 36384542.
- ^ "Robbins & Cotran Pathologic Basis of Disease – 9781455726134 | US Elsevier Health Bookshop". www.us.elsevierhealth.com. Archived from the original on 27 April 2021. Retrieved 26 October 2016.
- ^ Klatt EC (8 September 2011). Robbins and Cotran Atlas of Pathology. Elsevier Health Sciences. ISBN 978-1-4557-2683-7. Archived from the original on 10 September 2017.
- ^ Frigyesi I, Adolfsson J, Ali M, Christophersen MK, Johnsson E, Turesson I, et al. (February 2014). "Robust isolation of malignant plasma cells in multiple myeloma". Blood. 123 (9): 1336–1340. doi:10.1182/blood-2013-09-529800. PMID 24385542.
- ^ "Mayo Stratification for Myeloma And Risk-adapted Therapy". nebula.wsimg.com. Archived from the original on 28 August 2021. Retrieved 29 September 2017.
- ^ Sonneveld P, Avet-Loiseau H, Lonial S, Usmani S, Siegel D, Anderson KC, et al. (June 2016). "Treatment of multiple myeloma with high-risk cytogenetics: a consensus of the International Myeloma Working Group". Blood. 127 (24): 2955–2962. doi:10.1182/blood-2016-01-631200. PMC 4920674. PMID 27002115.
- ^ Angtuaco EJ, Fassas AB, Walker R, Sethi R, Barlogie B (April 2004). "Multiple myeloma: clinical review and diagnostic imaging". Radiology. 231 (1): 11–23. doi:10.1148/radiol.2311020452. PMID 14990813.
- ^ Nishida Y, Kimura S, Mizobe H, Yamamichi J, Kojima K, Kawaguchi A, et al. (October 2017). "Automatic digital quantification of bone marrow myeloma volume in appendicular skeletons - clinical implications and prognostic significance". Scientific Reports. 7 (1) 12885. Bibcode:2017NatSR...712885N. doi:10.1038/s41598-017-13255-w. PMC 5635114. PMID 29018236.
- ^ Kyle RA, Rajkumar SV (January 2009). "Criteria for diagnosis, staging, risk stratification and response assessment of multiple myeloma". Leukemia. 23 (1): 3–9. doi:10.1038/leu.2008.291. PMC 2627786. PMID 18971951.
- ^ a b c "International Myeloma Working Group (IMWG) Criteria for the Diagnosis of Multiple Myeloma". International Myeloma Working Group. 29 October 2015. Archived from the original on 7 November 2017. Retrieved 5 August 2018.
- ^ a b Greipp PR, San Miguel J, Durie BG, Crowley JJ, Barlogie B, Bladé J, et al. (May 2005). "International staging system for multiple myeloma". Journal of Clinical Oncology. 23 (15): 3412–3420. doi:10.1200/JCO.2005.04.242. PMID 15809451.
- ^ a b c Costa LJ, Usmani SZ (December 2020). "Defining and Managing High-Risk Multiple Myeloma: Current Concepts". Journal of the National Comprehensive Cancer Network. 18 (12): 1730–1737. doi:10.6004/jnccn.2020.7673. PMID 33285523.
- ^ Palumbo A, Avet-Loiseau H, Oliva S, Lokhorst HM, Goldschmidt H, Rosinol L, et al. (September 2015). "Revised International Staging System for Multiple Myeloma: A Report From International Myeloma Working Group". Journal of Clinical Oncology. 33 (26): 2863–2869. doi:10.1200/JCO.2015.61.2267. PMC 4846284. PMID 26240224.
- ^ Liedtke M, Fonseca R (2019). "Chapter 25: Plasma cell disorders". In Cuker A, Altman J, Gerds A, Wun T (eds.). American Society of Hematology Self-Assessment Program (Seventh ed.). American Society of Hematology. pp. 722–69. ISBN 978-0-9789212-4-8.
- ^ Lauby-Secretan B, Scoccianti C, Loomis D, Grosse Y, Bianchini F, Straif K (August 2016). "Body Fatness and Cancer--Viewpoint of the IARC Working Group". The New England Journal of Medicine. 375 (8): 794–798. doi:10.1056/NEJMsr1606602. PMC 6754861. PMID 27557308.
- ^ a b Rajkumar SV (8 December 2012). "Doublets, triplets, or quadruplets of novel agents in newly diagnosed myeloma?". Hematology. American Society of Hematology. Education Program. 2012: 354–361. doi:10.1182/asheducation.V2012.1.354.3798330. PMID 23233604. Archived from the original on 11 June 2023. Retrieved 10 June 2023.
- ^ Rubinstein SM (28 January 2020). "Standardizing Chemotherapy Regimen Nomenclature: A Proposal and Evaluation of the HemOnc and National Cancer Institute Thesaurus Regimen Content". JCO Clinical Cancer Informatics. 4 (4): 60–70. doi:10.1200/CCI.19.00122. PMC 7000232. PMID 31990580.
- ^ "Drug Therapy for Multiple Myeloma". American Cancer Society. Archived from the original on 11 June 2023. Retrieved 10 June 2023.
- ^ "What Is DARZALEX®?". 9 April 2021. Archived from the original on 11 June 2023. Retrieved 10 June 2023.
- ^ "Watchful waiting for multiple myeloma". Canadian Cancer Society. Archived from the original on 11 June 2023. Retrieved 10 June 2023.
- ^ "Triplet and Quadruplet Regimens in Smoldering Multiple Myeloma". 10 March 2023. Archived from the original on 11 June 2023. Retrieved 10 June 2023.
- ^ "Aggressive Smoldering Curative Approach Evaluating Novel Therapies and Transplant (ASCENT)". Archived from the original on 3 June 2023. Retrieved 3 June 2023.
- ^ "Immuno-PRISM (PRecision Intervention Smoldering Myeloma)". Archived from the original on 3 June 2023. Retrieved 3 June 2023.
- ^ "Getting a Stem Cell or Bone Marrow Transplant". American Cancer Society. Archived from the original on 10 June 2023. Retrieved 10 June 2023.
- ^ Kamboj M (1 June 2020). "Vaccination of the Stem Cell Transplant (SCT) recipient and the Hematologic Malignancy patient". Infectious Disease Clinics of North America. 33 (2): 593–609. doi:10.1016/j.idc.2019.02.007. PMC 6814287. PMID 31005140.
- ^ a b Pan D (20 January 2022). "Where We Stand With Precision Therapeutics in Myeloma: Prosperity, Promises, and Pipedreams". Frontiers in Oncology. 11 819127. doi:10.3389/fonc.2021.819127. PMC 8811139. PMID 35127532.
- ^ Kumar S (2020). "Updated results from BELLINI, a phase III study of venetoclax or placebo in combination with bortezomib and dexamethasone in relapsed/refractory multiple myeloma". Journal of Clinical Oncology. 38 (15_suppl): 8509. doi:10.1200/JCO.2020.38.15_suppl.8509. S2CID 219779811. Archived from the original on 18 August 2023. Retrieved 3 June 2023.
- ^ "FDA Approves BCMA-Targeted CAR T-Cell Therapy for Multiple Myeloma". National Cancer Institute. 14 April 2021. Archived from the original on 11 June 2023. Retrieved 10 June 2023.
- ^ "Carvykti Approval Marks Second CAR T-Cell Therapy for Multiple Myeloma". National Cancer Institute. 30 March 2022. Archived from the original on 10 June 2023. Retrieved 10 June 2023.
- ^ "FDA Expands CAR T Approvals for Patients With Multiple Myeloma". Association for the Advancement of Blood & Biotherapies. 9 April 2024. Retrieved 28 March 2025.
- ^ "FDA approves teclistamab-cqyv for relapsed or refractory multiple myeloma". U.S. Food and Drug Administration. 25 October 2022. Archived from the original on 27 October 2022. Retrieved 10 June 2023.
- ^ Chari A (15 December 2022). "Talquetamab, a T-Cell–Redirecting GPRC5D Bispecific Antibody for Multiple Myeloma". New England Journal of Medicine. 387 (24): 2232–2244. doi:10.1056/NEJMoa2204591. PMID 36507686. S2CID 254560960.
- ^ Korde N, Kristinsson SY, Landgren O (May 2011). "Monoclonal gammopathy of undetermined significance (MGUS) and smoldering multiple myeloma (SMM): novel biological insights and development of early treatment strategies". Blood. 117 (21): 5573–5581. doi:10.1182/blood-2011-01-270140. PMC 3316455. PMID 21441462.
- ^ Kyle RA, Rajkumar SV (March 2008). "Multiple myeloma". Blood. 111 (6): 2962–2972. doi:10.1182/blood-2007-10-078022. PMC 2265446. PMID 18332230.
- ^ Printz C (20 September 2016). "Study: Stem cell transplant should remain preferred therapy for multiple myeloma". Cancer. 122 (19): 2937. doi:10.1002/cncr.30334. ISSN 0008-543X. S2CID 78285186.
- ^ "Stem Cell Transplant for Multiple Myeloma". www.cancer.org. Archived from the original on 13 October 2019. Retrieved 13 October 2019.
- ^ San Miguel JF, Schlag R, Khuageva NK, Dimopoulos MA, Shpilberg O, Kropff M, et al. (August 2008). "Bortezomib plus melphalan and prednisone for initial treatment of multiple myeloma". The New England Journal of Medicine. 359 (9): 906–917. doi:10.1056/NEJMoa0801479. hdl:10261/59573. PMID 18753647.
- ^ Curran MP, McKeage K (May 2009). "Bortezomib: a review of its use in patients with multiple myeloma". Drugs. 69 (7): 859–888. doi:10.2165/00003495-200969070-00006. PMID 19441872.
- ^ Durie BG (August 2008). "Treatment of myeloma--are we making progress?". The New England Journal of Medicine. 359 (9): 964–966. doi:10.1056/NEJMe0805176. PMID 18753654.
- ^ a b Mateos MV, San-Miguel J, Cavo M, Suzuki K, Jakubowiak A, Knop S, Doyen C, Lucio P, Nagy Z, Pour L, Grosicki S, Crepaldi A, Liberati AM, Campbell P, Yoon SS, Iosava G, Fujisaki T, Garg M, Ngo M, Katz EG, Krevvata M, Bolyard K, Carson R, Borgsten F, Dimopoulos MA (May 2025). "Bortezomib, melphalan, and prednisone with or without daratumumab in transplant-ineligible patients with newly diagnosed multiple myeloma (ALCYONE): final analysis of an open-label, randomised, multicentre, phase 3 trial". The Lancet. Oncology. 26 (5): 596–608. doi:10.1016/S1470-2045(25)00018-X. PMID 40220771.
- ^ San-Miguel J, Avet-Loiseau H, Paiva B, Kumar S, Dimopoulos MA, Facon T, Mateos MV, Touzeau C, Jakubowiak A, Usmani SZ, Cook G, Cavo M, Quach H, Ukropec J, Ramaswami P, Pei H, Qi M, Sun S, Wang J, Krevvata M, DeAngelis N, Heuck C, Van Rampelbergh R, Kudva A, Kobos R, Qi M, Bahlis NJ (January 2022). "Sustained minimal residual disease negativity in newly diagnosed multiple myeloma and the impact of daratumumab in MAIA and ALCYONE". Blood. 139 (4): 492–501. doi:10.1182/blood.2020010439. PMC 8796656. PMID 34269818.
- ^ a b Piechotta V, Jakob T, Langer P, Monsef I, Scheid C, Estcourt LJ, et al. (Cochrane Haematology Group) (November 2019). "Multiple drug combinations of bortezomib, lenalidomide, and thalidomide for first-line treatment in adults with transplant-ineligible multiple myeloma: a network meta-analysis". The Cochrane Database of Systematic Reviews. 2019 (11). doi:10.1002/14651858.CD013487. PMC 6876545. PMID 31765002.
- ^ Abraham J (February 2009). "Advances in multiple myeloma treatment: lenalidomide and bortezomib". Community Oncology. 6 (2): 53–55. doi:10.1016/S1548-5315(11)70208-X.
- ^ Sonneveld P, Dimopoulos MA, Boccadoro M, Quach H, Ho PJ, Beksac M, Hulin C, Antonioli E, Leleu X, Mangiacavalli S, Perrot A, Cavo M, Belotti A, Broijl A, Gay F (12 December 2023). "Daratumumab, Bortezomib, Lenalidomide, and Dexamethasone for Multiple Myeloma". New England Journal of Medicine. 390 (4): 301–313. doi:10.1056/NEJMoa2312054. hdl:11585/969802. ISSN 0028-4793. PMID 38084760. S2CID 266217426.
- ^ Johnson WJ, Kyle RA, Pineda AA, O'Brien PC, Holley KE (April 1990). "Treatment of renal failure associated with multiple myeloma. Plasmapheresis, hemodialysis, and chemotherapy". Archives of Internal Medicine. 150 (4): 863–869. doi:10.1001/archinte.1990.00390160111022. PMID 2183734.
- ^ Paul M, Walker F, Bear RA (November 1982). "Plasmapheresis therapy in a patient with multiple myeloma". Canadian Medical Association Journal. 127 (10): 956. PMC 1862296. PMID 7139441.
- ^ McCarthy PL, Holstein SA, Petrucci MT, Richardson PG, Hulin C, Tosi P, et al. (October 2017). "Lenalidomide Maintenance After Autologous Stem-Cell Transplantation in Newly Diagnosed Multiple Myeloma: A Meta-Analysis". Journal of Clinical Oncology. 35 (29): 3279–3289. doi:10.1200/JCO.2017.72.6679. PMC 5652871. PMID 28742454.
- ^ Sonneveld P, Schmidt-Wolf IG, van der Holt B, El Jarari L, Bertsch U, Salwender H, et al. (August 2012). "Bortezomib induction and maintenance treatment in patients with newly diagnosed multiple myeloma: results of the randomized phase III HOVON-65/ GMMG-HD4 trial". Journal of Clinical Oncology. 30 (24): 2946–2955. doi:10.1200/JCO.2011.39.6820. hdl:1765/73197. PMID 22802322. Archived from the original on 18 August 2023. Retrieved 23 December 2022.
- ^ Rajkumar SV (June 2019). "Multiple myeloma: Every year a new standard?". Hematological Oncology. 37 (Suppl 1): 62–65. doi:10.1002/hon.2586. PMC 6570407. PMID 31187526.
- ^ "FDA granted accelerated approval to belantamab mafodotin-blmf for multiple myeloma". U.S. Food and Drug Administration (FDA). 5 August 2020. Archived from the original on 6 August 2020. Retrieved 6 August 2020.
 This article incorporates text from this source, which is in the public domain.
This article incorporates text from this source, which is in the public domain.
- ^ "FDA Approves GSK's BLENREP (belantamab mafodotin-blmf) for the Treatment of Patients with Relapsed or Refractory Multiple Myeloma" (Press release). GlaxoSmithKline. 6 August 2020. Retrieved 6 August 2020 – via Business Wire.
- ^ "Kyprolis (carfilzomib) for Injection, for Intravenous Use. Full Prescribing Information" (PDF). Thousand Oaks, CA: Onyx Pharmaceuticals. Archived from the original (PDF) on 23 October 2016. Retrieved 20 August 2016.
- ^ "Darzalex (daratumumab) Injection, for Intravenous Use. Full Prescribing Information" (PDF). Horsham, PA: Janssen Biotech. Archived from the original (PDF) on 18 August 2016. Retrieved 18 August 2016.
- ^ "Empliciti (elotuzumab) for Injection, for Intravenous Use. Full Prescribing Information" (PDF). Princeton, NJ: Bristol-Myers Squibb Company. Archived from the original (PDF) on 8 December 2015. Retrieved 18 August 2016.
- ^ "FDA approves isatuximab-irfc for multiple myeloma". U.S. Food and Drug Administration (FDA). 2 March 2020. Archived from the original on 5 March 2020. Retrieved 2 March 2020.
- ^ Martin TG, Corzo K, Chiron M, Velde HV, Abbadessa G, Campana F, et al. (November 2019). "Therapeutic Opportunities with Pharmacological Inhibition of CD38 with Isatuximab". Cells. 8 (12): 1522. doi:10.3390/cells8121522. PMC 6953105. PMID 31779273.
- ^ "Ninlaro (ixazomib) Capsules, for Oral Use. Full Prescribing Information" (PDF). Millennium Pharmaceuticals, Inc. Archived from the original (PDF) on 19 August 2016. Retrieved 18 August 2016.
- ^ "Farydak (panobinostat) Capsules, for Oral Use. Full Prescribing Information" (PDF). East Hanover, New Jersey: Novartis Pharmaceuticals Corporation. Archived from the original (PDF) on 22 October 2016. Retrieved 18 August 2016.
- ^ "Xpovio (selinexor) Tablets, for Oral Use. Full Prescribing Information" (PDF). Newton, MA: Karyopharm Therapeutics. Archived from the original (PDF) on 3 August 2019. Retrieved 3 August 2019.
- ^ a b "FDA Approves First Cell-Based Gene Therapy for Adult Patients with Multiple Myeloma" (Press release). US Food and Drug Administration; FDA. 27 March 2021. Archived from the original on 27 March 2021.
- ^ "FDA grants accelerated approval to talquetamab-tgvs for relapsed or refractory multiple myeloma". U.S. Food and Drug Administration (FDA). 9 August 2023. Archived from the original on 11 August 2023. Retrieved 10 August 2023.
- ^ "U.S. FDA Approves Talvey (talquetamab-tgvs), a First-in-Class Bispecific Therapy for the Treatment of Patients with Heavily Pretreated Multiple Myeloma" (Press release). Janssen. 10 August 2023. Retrieved 17 August 2023 – via PR Newswire.
- ^ "FDA grants accelerated approval to elranatamab-bcmm for multiple myeloma". U.S. Food and Drug Administration (FDA) (Press release). 14 August 2023. Archived from the original on 15 August 2023. Retrieved 14 August 2023.
- ^ "Pfizer's Elrexfio Receives U.S. FDA Accelerated Approval for Relapsed or Refractory Multiple Myeloma" (Press release). Pfizer. 14 August 2023. Retrieved 17 August 2023 – via Business Wire.
- ^ a b c Fisher SA, Cutler A, Doree C, Brunskill SJ, Stanworth SJ, Navarrete C, Girdlestone J, et al. (Cochrane Haematological Malignancies Group) (January 2019). "Mesenchymal stromal cells as treatment or prophylaxis for acute or chronic graft-versus-host disease in haematopoietic stem cell transplant (HSCT) recipients with a haematological condition". The Cochrane Database of Systematic Reviews. 1 (1) CD009768. doi:10.1002/14651858.CD009768.pub2. PMC 6353308. PMID 30697701.
- ^ a b "FDA approves ciltacabtagene autoleucel for relapsed or refractory multiple myeloma". U.S. Food and Drug Administration (FDA). 7 March 2022. Archived from the original on 17 March 2022. Retrieved 16 March 2022.
 This article incorporates text from this source, which is in the public domain.
This article incorporates text from this source, which is in the public domain.
- ^ Estcourt L, Stanworth S, Doree C, Hopewell S, Murphy MF, Tinmouth A, Heddle N, et al. (Cochrane Haematological Malignancies Group) (May 2012). "Prophylactic platelet transfusion for prevention of bleeding in patients with haematological disorders after chemotherapy and stem cell transplantation". The Cochrane Database of Systematic Reviews (5) CD004269. doi:10.1002/14651858.CD004269.pub3. PMC 11972837. PMID 22592695.
- ^ Estcourt LJ, Stanworth SJ, Doree C, Hopewell S, Trivella M, Murphy MF, et al. (Cochrane Haematological Malignancies Group) (November 2015). "Comparison of different platelet count thresholds to guide administration of prophylactic platelet transfusion for preventing bleeding in people with haematological disorders after myelosuppressive chemotherapy or stem cell transplantation". The Cochrane Database of Systematic Reviews. 2015 (11) CD010983. doi:10.1002/14651858.CD010983.pub2. PMC 4717525. PMID 26576687.
- ^ a b c Knips L, Bergenthal N, Streckmann F, Monsef I, Elter T, Skoetz N, et al. (Cochrane Haematological Malignancies Group) (January 2019). "Aerobic physical exercise for adult patients with haematological malignancies". The Cochrane Database of Systematic Reviews. 1 (1) CD009075. doi:10.1002/14651858.CD009075.pub3. PMC 6354325. PMID 30702150.
- ^ The American Society of Clinical Oncology has made this recommendation based on various cancers. See American Society of Clinical Oncology, "Five Things Physicians and Patients Should Question" (PDF), Choosing Wisely: an initiative of the ABIM Foundation, American Society of Clinical Oncology, archived from the original (PDF) on 31 July 2012, retrieved 14 August 2012
- ^ Snowden JA, Ahmedzai S, Ashcroft J, et al. (2010). "Guidelines for Supportive Care in Myeloma" (PDF). British Committee for Standards in Haematology. Archived from the original (PDF) on 23 September 2015. Retrieved 21 August 2014.
- ^ Higginson IJ, Evans CJ (2010). "What is the evidence that palliative care teams improve outcomes for cancer patients and their families?". Cancer Journal. 16 (5): 423–435. doi:10.1097/PPO.0b013e3181f684e5. PMID 20890138. S2CID 39881122.
- ^ Lorenz KA, Lynn J, Dy SM, Shugarman LR, Wilkinson A, Mularski RA, et al. (January 2008). "Evidence for improving palliative care at the end of life: a systematic review". Annals of Internal Medicine. 148 (2): 147–159. doi:10.7326/0003-4819-148-2-200801150-00010. PMID 18195339.
- ^ Abed H, Burke M, Nizarali N (2 May 2018). "Oral and dental management for people with multiple myeloma: clinical guidance for dental care providers". Dental Update. 45 (5): 383–399. doi:10.12968/denu.2018.45.5.383. ISSN 0305-5000.
- ^ a b "Myeloma—Cancer Stat Facts". SEER. Archived from the original on 7 May 2020. Retrieved 17 April 2020.
- ^ Avet-Loiseau H, Li C, Magrangeas F, Gouraud W, Charbonnel C, Harousseau JL, et al. (September 2009). "Prognostic significance of copy-number alterations in multiple myeloma". Journal of Clinical Oncology. 27 (27): 4585–4590. doi:10.1200/JCO.2008.20.6136. PMC 2754906. PMID 19687334.
- ^ Jurczyszyn A, Charliński G, Suska A, Vesole DH (2021). "The importance of cytogenetic and molecular aberrations in multiple myeloma". Acta Haematologica Polonica. 52 (4): 361–370. doi:10.5603/AHP.2021.0069.
- ^ "WHO Disease and injury country estimates". World Health Organization. 2009. Archived from the original on 11 November 2009. Retrieved 11 November 2009.
- ^ a b Cowan et al. 2022, p. 464.
- ^ Collins CD (November 2005). "Problems monitoring response in multiple myeloma". Cancer Imaging. 5 Spec No A (Spec No A): S119 – S126. doi:10.1102/1470-7330.2005.0033. PMC 1665317. PMID 16361127.
- ^ "Key Statistics About Multiple Myeloma". American Cancer Society. 28 February 2025. Retrieved 27 November 2025.
- ^ a b c Munshi, Longo & Anderson 2022, p. 868.
- ^ "Myeloma statistics". Cancer Research UK. Archived from the original on 28 October 2014. Retrieved 28 October 2014.
- ^ Rosenberg PS, Barker KA, Anderson WF (6 December 2014). "Future Burden of Multiple Myeloma in the United States". Blood. 124 (21). American Society of Hematology: 1292. doi:10.1182/blood.v124.21.1292.1292. ISSN 0006-4971.
- ^ Ettinger SJ, Feldman EC (1 June 2000). Textbook of Veterinary Internal Medicine: Diseases of the Dog and Cat. Vol. 1. W.B. Saunders. pp. 516–9. ISBN 978-0-7216-7257-1.
- ^ MacAllister C, Qualls C, Tyler R, Root CR (August 1987). "Multiple myeloma in a horse". Journal of the American Veterinary Medical Association. 191 (3): 337–339. doi:10.2460/javma.1987.191.03.337. PMID 3654300.
- ^ a b c Matus RE, Leifer CE, MacEwen EG, Hurvitz AI (June 1986). "Prognostic factors for multiple myeloma in the dog". Journal of the American Veterinary Medical Association. 188 (11): 1288–1292. doi:10.2460/javma.1986.188.11.1288. PMID 3721983.
- ^ MacEwen EG, Hurvitz AI (February 1977). "Diagnosis and management of monoclonal gammopathies". The Veterinary Clinics of North America. 7 (1): 119–132. doi:10.1016/S0091-0279(77)50010-X. PMID 403649.
Works Cited
- Cowan AJ, Green DJ, Kwok M, Lee S, Coffey DG, Holmberg LA, Tuazon S, Gopal AK, Libby EN (February 2022). "Diagnosis and Management of Multiple Myeloma: A Review". JAMA. 327 (5): 464–477. doi:10.1001/jama.2022.0003. PMID 35103762.
- Malard F, Neri P, Bahlis NJ, Terpos E, Moukalled N, Hungria VT, Manier S, Mohty M (June 2024). "Multiple myeloma". Nat Rev Dis Primers. 10 (1) 45. doi:10.1038/s41572-024-00529-7. PMID 38937492.
- Munshi NC, Longo DL, Anderson KC (2022). "111: Plasma Cell Disorders". In Loscalzo J, Fauci A, Kasper D, et al. (eds.). Harrison's Principles of Internal Medicine (21 ed.). McGraw Hill. ISBN 978-1-264-26850-4.
van de Donk NW, Pawlyn C, Yong KL (January 2021). "Multiple myeloma". Lancet. 397 (10272): 410–427. doi:10.1016/S0140-6736(21)00135-5. PMID 33516340.